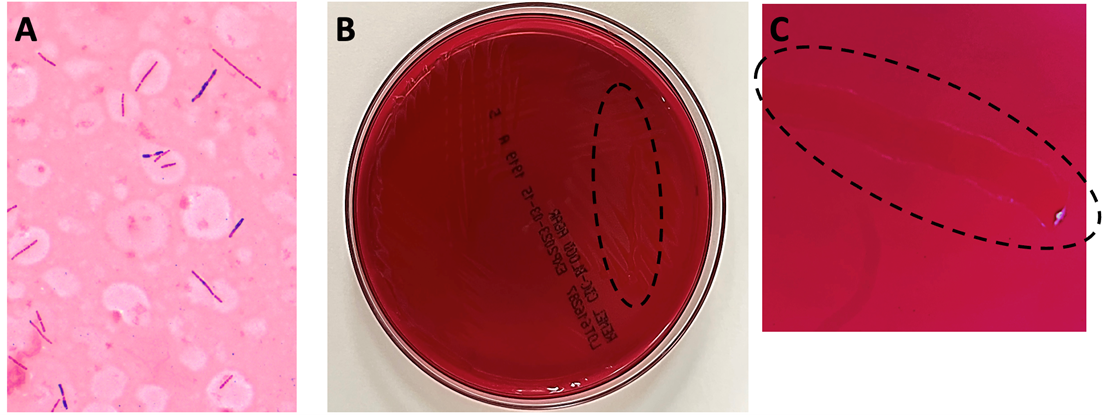

Case History
A 25 year old male with severe right lower quadrant abdominal pain, fever and history of congenital neutropenia and thrombocytopenia presented to the emergency department. The patient reported experiencing similar episodes over the previous six months, sometimes requiring hospitalization. His symptoms would typically improve following several days of antibiotic therapy and were thought to be secondary to typhlitis. He reported that his current symptomology was more severe than any of the previous episodes. In the emergency department, the patient was found to be tachycardic and severely hypotensive, prompting admission for sepsis and empiric antimicrobial therapy with piperacillin/tazobactam and vancomycin. Imaging at the time revealed severe terminal ileitis with mild pancolitis, markedly worsened from a study obtained months prior during a previous episode. After failing to improve with conservative management, an exploratory laparotomy with total abdominal colectomy and end ileostomy was completed to achieve source control.
Laboratory workup
Anaerobic bottles from blood cultures collected at the time of hospital admission flagged positive in under 24 hours. Gram staining from the positive bottle broth revealed large, gram variable bacilli (Image 1A). Multiplex PCR performed on the positive blood culture broth failed to reveal the identity of the organism. After 24 hours, close observation was required to visualize bacterial growth on anaerobic blood culture media, which appeared as a thin, translucent film (Image 1B). To provide better visualization for this case, a loop was utilized to scrape the growth so a path could be observed within the biomass (Images 1B and 1C, dotted lines). The bacterium recovered was definitively identified as Clostridium septicum by MALDI-TOF MS, prompting continued coverage with piperacillin/tazobactam until discharge.
Discussion
Clostridium septicum is an anaerobic, Gram-positive spore-forming bacillus.1,2 Colony morphology on solid media evolves over time, with a characteristic “medusa head” morphology at under 8 hours, a “sand grain” appearance at approximately 24 hours, and visible swarming after 48 hours (Image 1B and 1C).2 The organism is found in the soil and the gastrointestinal tracts of both humans and animals with the potential to cause a variety of diseases. It is especially problematic as an infectious agent of livestock and other ruminants, poultry, and horses.1 Clinical manifestations of infection with C. septicum in humans includes necrotizing enterocolitis, bacteremia, and clostridial myonecrosis.2 Prompt identification of infection with Clostridium septicum is essential due to the rapidly fatal nature of untreated bacteremia with this organism. The mainstay of treatment is early initiation of antibiotic therapy and aggressive surgical debridement of affected tissue. The drug of choice for medical management is penicillin, although metronidazole and carbapenems may be used in patients with penicillin allergies.
C. perfringens and C. septicum are the two clostridial species most associated with bacteremia in neutropenic patients.5 Clostridium septicum bacteremia can allow for the hematogenous dissemination of infection and can be rapidly fatal.3 Infection of the bowels of a susceptible host and compromise to the bowel wall integrity leads to entry of bacteria into the circulation. In severe cases, this in turn can lead to seeding of distal sites with progression to sequelae including clostridial myonecrosis (gas gangrene). While classical traumatic myonecrosis associated with an infected wound becomes contaminated with clostridial spores from the external environment (most commonly C. perfringens), atraumatic (or spontaneous) myonecrosis is associated with C. septicum (among other clostridial species) and results from hematogenous seeding of distal sites during bacteremia. Virulence and tissue necrosis are mediated by a variety of exotoxins produced by the organism,1 with alpha-toxin being the primary virulence determinant.4
Importantly, Clostridium septicum bacteremia is strongly associated with both hematogenous and gastrointestinal cancers. For this reason, detection of this pathogen in the blood may warrant further patient evaluation for potential sources of underlying pathology.2 In this patient’s case, typhlitis and neutropenic enterocolitis were precipitating factors leading to his C. septicum bacteremia as this patient presented without evidence of gastrointestinal malignancy. Following the procedure, the patient stabilized, and his condition continued to improve through recovery. His antibiotics were eventually discontinued, and he was discharged.
References
- Alves MLF, Ferreira MRA, Donassolo RA, Rodrigues RR, Conceição FR. Clostridium septicum: A review in the light of alpha-toxin and development of vaccines. Vaccine. 2021;39(35):4949-4956. doi:10.1016/j.vaccine.2021.07.019
- Mallozzi MJG, Clark AE. Trusting your gut: Diagnosis and management of clostridium septicum infections. Clinical Microbiology Newsletter. 2016;38(23):187-191. doi:10.1016/j.clinmicnews.2016.11.001
- Koransky JR, Stargel MD, Dowell VR Jr. Clostridium septicum bacteremia. Its clinical significance. Am J Med. 1979;66(1):63-66. doi:10.1016/0002-9343(79)90483-2
- Kennedy CL, Krejany EO, Young LF, et al. The alpha-toxin of Clostridium septicum is essential for virulence. Mol Microbiol. 2005;57(5):1357-1366. doi:10.1111/j.1365-2958.2005.04774.x
- Bennet JE, Dolin R, Blaser MJ, Onderdonk AB, Garrett WS. Diseases Caused by Clostridium. In Mandell, Douglas, and Bennett’s principles and practice of infectious diseases (2nd ed., pp. 2960-2968). Elsevier.

-Amanda Means is a PGY-1 resident in Anatomic and Clinical Pathology at the University of Texas Southwestern Medical Center in Dallas, Texas. Dr. Means did her undergraduate studies at Sam Houston St University in Huntsville, TX and received her medical degree from the University of Texas Health Sciences Center in San Antonio.

-Clare McCormick-Baw, MD, PhD is an Assistant Professor of Clinical Microbiology at UT Southwestern in Dallas, Texas. She has a passion for teaching about laboratory medicine in general and the best uses of the microbiology lab in particular.

-Andrew Clark, PhD, D(ABMM) is an Assistant Professor at UT Southwestern Medical Center in the Department of Pathology, and Associate Director of the Clements University Hospital microbiology laboratory. He completed a CPEP-accredited postdoctoral fellowship in Medical and Public Health Microbiology at National Institutes of Health, and is interested in antimicrobial susceptibility and anaerobe pathophysiology.